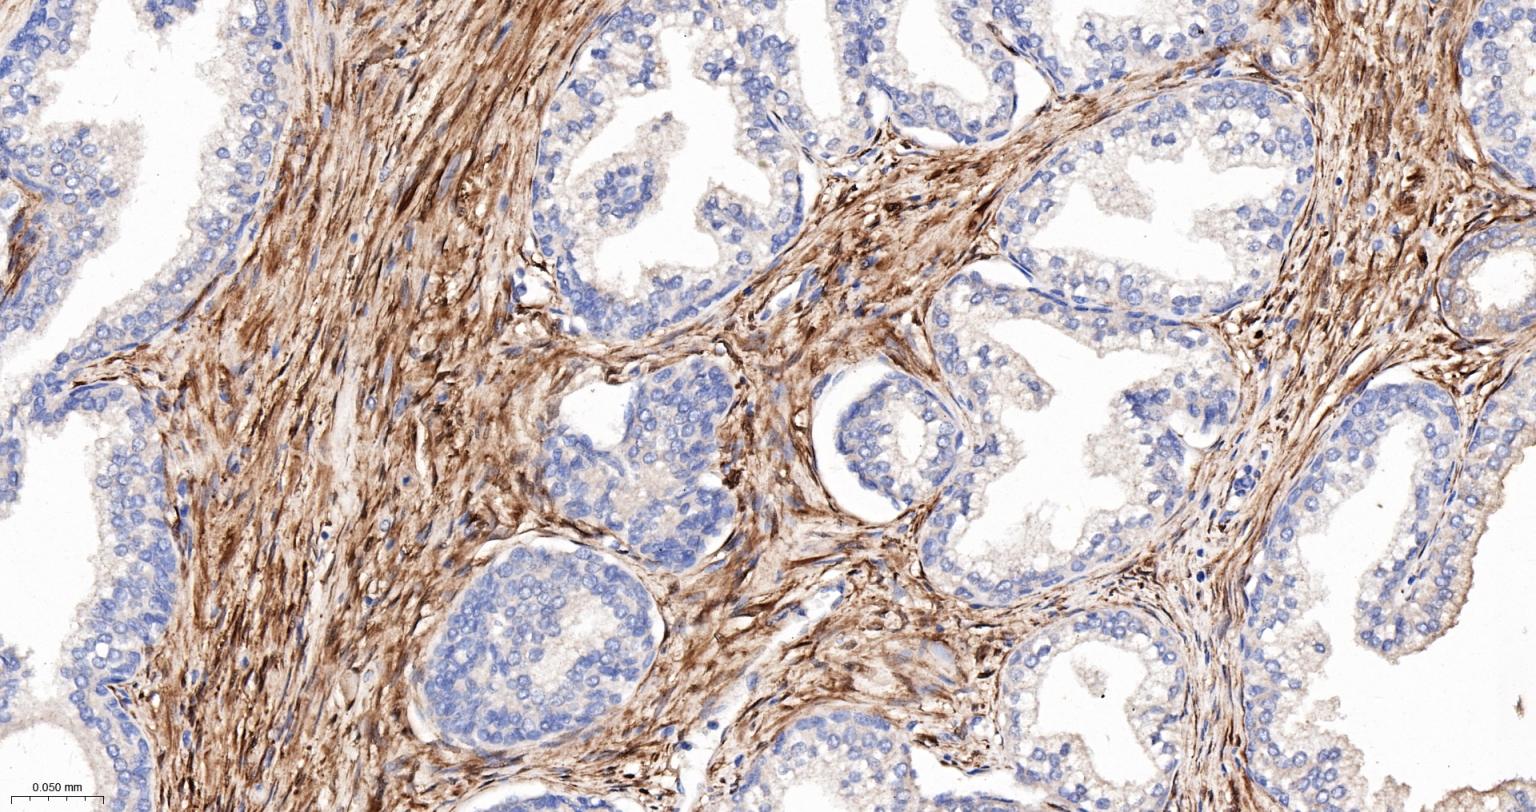
热休克蛋白-20重组兔单抗

热休克蛋白-20重组兔单抗
Rrmab?兔单抗

货号:bsm-61344R
产品详情
相关标记
相关产品
相关文献
常见问题
概述
产品编号
bsm-61344R
产品类型
重组兔单抗
英文名称
HSPB6 Recombinant Rabbit mAb
中文名称
热休克蛋白-20重组兔单抗
英文别名
HEL55; Hsp20; PPP1R91; Gm479; p20; HSPB6_HUMAN; HSPB6; Heat shock 20 kDa-like protein p20; Heat shock protein family B member 6; Q6NVI3_HUMAN; HSPB6_MOUSE; HSPB6_RAT; Heat shock 20 kDa-like protein p20 (Hsp20);
抗体来源
Rabbit
免疫原
A synthesized peptide derived from human Hsp20: 90-160/160
亚型
IgG
性状
Liquid
纯化方法
affinity purified by Protein A
克隆类型
Recombinant
克隆号
1H10
理论分子量
17 kDa
检测分子量
17 kDa
储存液
10mM phosphate buffered saline(pH 7.4) with 150mM sodium chloride, 0.05% BSA, 0.02% Proclin300 and 50% glycerol.
研究领域
SWISS
Gene ID
保存条件
Store at 4℃ for short term. Store at -20℃ for long term. Avoid repeated freeze/thaw cycles.
注意事项
This product as supplied is intended for research use only, not for use in human, therapeutic or diagnostic applications.
数据库链接
产品介绍
HSPs是细胞受应激原刺激后诱导产生的一组应激蛋白,与肿瘤发生、增殖及分化有关。按其分子量不同可分为多种类型,每组的HSPs的分布及功能有所不同。
背景资料
Small heat shock protein which functions as a molecular chaperone probably maintaining denatured proteins in a folding-competent state. Seems to have versatile functions in various biological processes.

产品应用
| 应用 | 已检合格种属 | 预测种属 | 推荐稀释比例 |
|---|---|---|---|
| WB | Human, Mouse, Rat | 1:500-2000 | |
| IHC-P | Human, Mouse, Rat | 1:100-500 | |
| IHC-F | Human, Mouse, Rat | 1:100-500 | |
| IF | Human, Mouse, Rat | 1:100-500 | |
| Flow-Cyt | Human, Mouse, Rat | 1:50-100 |
交叉反应
交叉反应: Human, Mouse, Rat
相关产品
暂无相关产品
靶标
基因名
HSPB6
蛋白名
Heat shock protein beta-6
亚基
Homodimer (By similarity).
亚细胞定位
Cytoplasm. Nucleus. Note=Translocates to nuclear foci during heat shock.
翻译后修饰
The N-terminus is blocked.
相似性
Belongs to the small heat shock protein (HSP20) family.
标记抗体
暂无标记数据
同靶标产品
暂无同靶标产品
相关文献
提示: 发表研究结果有使用 bsm-61344R 时请让我们知道,以便我们可以引用参考文章。作为回馈,资料提供者将获得我们送上的小礼品。
暂无相关文献
常见问题
暂无常见问题